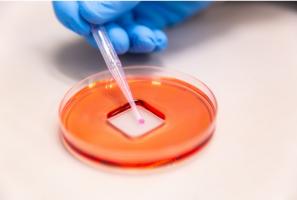
Un revêtement par pulvérisation qui protège les surfaces contre les virus et les bactéries (Visuel Cesar Nicolas, University of Melbourne)

Vous recherchez une actualité ou un dossier
Recherche (liste)
Mode d'affichage :
-
COVID-19 : Alors quelle efficacité de la vitamine D ?
Actualité publiée le 11/09/2022COVID-19 : De faibles niveaux de testostérone dans les formes graves
Actualité publiée le 07/09/2022
-
OMICRON : Le 3è rappel pour 3 mois ?
Actualité publiée le 05/09/2022COVID long : Le syndrome de fatigue chronique n’est pas une illusion
Actualité publiée le 05/09/2022
-
COVID-19 : Il continue à faire baisser l'espérance de vie
Actualité publiée le 04/09/2022COVID RADAR : Le séquençage génétique prédit la virulence du prochain variant
Actualité publiée le 03/09/2022
-
COVID-19 : L'infection par les variantes précédentes offre une bonne protection contre Omicron
Actualité publiée le 02/09/2022COVID-19 : Compter les antigènes pour connaître sa sévérité
Actualité publiée le 01/09/2022
-
ALZHEIMER : Le COVID long favorise-t-il le déclin cognitif ?
Actualité publiée le 01/09/2022COVID-19 : Cannabis et hallucinogènes, leur usage marque aussi un pic pandémique
Actualité publiée le 28/08/2022
-
VARIOLE du SINGE, SIDA et COVID-19, mêmes défis ?
Actualité publiée le 28/08/2022COVID-19 : Découverte d’un nouveau facteur de sévérité majeur
Actualité publiée le 27/08/2022
-
COVID : Un risque plus élevé de myocardite, après infection ou après vaccination ?
Actualité publiée le 26/08/2022COVID-19 : L’incidence du diabète bondit chez les enfants durant la pandémie
Actualité publiée le 26/08/2022
-
COVID-19 : Des effets sur le développement social du petit enfant ?
Actualité publiée le 26/08/2022COVID-19 : Différentes souches, différentes périodes d’incubation ?
Actualité publiée le 24/08/2022
-
INSUFFISANCE CARDIAQUE : Les vaccins COVID à ARNm sont-ils sûrs ?
Actualité publiée le 23/08/2022COVID-19 : Contagiosité, alors quelle durée ?
Actualité publiée le 22/08/2022
-
COVID LONG : Chez l’Enfant aussi
Actualité publiée le 16/08/2022COVID-19 : La vie est-elle vraiment revenue à la normale ?
Actualité publiée le 10/08/2022
-
COVID LONG : Fatigue et maux de tête, les principaux symptômes persistants
Actualité publiée le 09/08/2022COVID LONG : Symptômes et prévalence, dernières estimations
Actualité publiée le 08/08/2022
-
COVID LONG : Et si l’infection ne s’arrêtait pas ?
Actualité publiée le 04/08/2022COVID-19 : Le nez de l’enfant inspire une protection contre l'infection
Actualité publiée le 04/08/2022
-
COVID-19 : Redonner de l'énergie aux cellules immunitaires ?
Actualité publiée le 03/08/2022COVID-19 : Dysgueusie, anosmie, 27 millions de personnes ont perdu goût à tout
Actualité publiée le 02/08/2022
-
COVID-19 : Un spray de nanofils de cuivre pour décontaminer les surfaces
Actualité publiée le 02/08/2022VACCIN COVID-19 : Et si le patch marchait mieux que l’aiguille ?
Actualité publiée le 31/07/2022
-
COVID-19 : Pourquoi l’ivermectine fait toujours débat
Actualité publiée le 31/07/2022COVID-19 : L’édition du génome identifie les gènes de vulnérabilité
Actualité publiée le 30/07/2022
-
COVID-19 : Les coronavirus du rhume nous ont-ils déjà donné un peu d’immunité ?
Actualité publiée le 29/07/2022COVID-19 : Le revêtement par pulvérisation qui fait bouclier contre le virus
Actualité publiée le 29/07/2022
-
GROSSESSE et COVID-19 : Sur le risque accru de naissance prématurée
Actualité publiée le 28/07/2022VACCIN COVID : Il n’affecte pas la santé du placenta
Actualité publiée le 28/07/2022
Pages